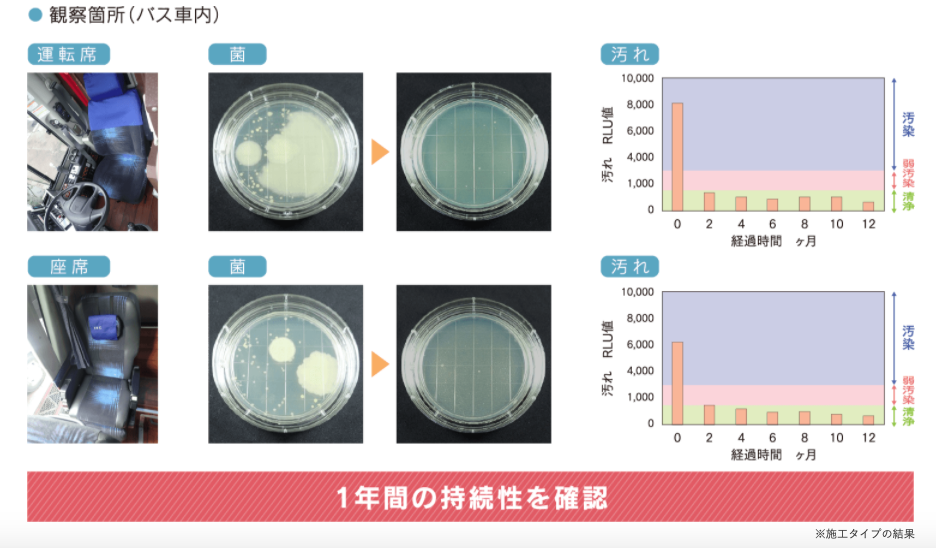

業務に使えるトラックはコチラ!
展示場への入庫と検品の概要についてご紹介

▲今回は中部展示場にご協力頂きました!
今回の記事は、三重県四日市市に店舗を構える、トラック王国中部展示場にご協力頂きました!
国道23号線沿線・四日市市の南側に位置する中型展示場では、常時50台から80台のトラックが展示されています。 工業地帯が近い事から、日々お客様からトラックのご用命を頂いております!
さて、今回は中型展示場を舞台に、トラック王国にトラックが入庫してから点検を経て、最終的に納品されるまでの流れをご紹介したいと思います!
展示場のトラックがどのような流れで店頭に並ぶかを、イメージして貰えれば幸いです。
入庫から納車までの流れについて
まずは入庫から納車までの流れを、時系列で紹介していきます!展示場での大枠の段取りは、以下のようになっています。
入庫から納車までの大枠の段取り
- ①入庫
- ②検品
- ③室内清掃
- ④現車確認
- ⑤再清掃
- ⑥納車前点検
- ⑦納車
トラック王国では納車前にも、再度清掃と点検を行っております!
トラックの検品について

▲点検は隅々まで行われています
車両が入庫してから行われる検品の内容は、以下のようになっています! 検品表のチェック項目は、エンジンやブレーキ、灯火類など200箇所以上であり、この項目はお客様の声を元に更新されています。
- 検品表のチェック項目抜粋
- エンジン始動性
- 排気ガスの色
- MTの種類
- ガラスの飛石など
また、内外装の装備に不備が無いかを、内外装チェックシートを使って確認します。内外装シートは車種によってチェック項目が異なり、平ボディの場合は以下のようなチェック項目があります。
- 平ボディの内外装チェックシート抜粋
- 集中ドアロック
- 燃焼装置
- 上物情報(メーカー・型式など)
- 荷台状態(床フック・ロープ穴など)
清掃の模様をご紹介!トラック王国のクリーニング例

▲車体の隅々まで清掃が行われます
清掃時は高圧洗浄機などを利用してしつこい汚れを落とすことに集中しています!
ここからは、車体の清掃を行う際の流れなどについて! 中部展示場からの回答を基に、清掃のポイントをお伝えしていきます。
清掃の流れについて

▲高圧洗浄機を活用しています
トラック王国の車両清掃時は、基本的な清掃は無料で、一部の清掃は有料になります。清掃内容の詳細は、各展示場にお問い合わせください。
Q1.清掃箇所の汚れについて
トラックの内装・外装で、汚れが落ちにくい部分はどんな箇所でしょうか?特に汚れが落ちにくい部分があれば、教えて頂きたいです。
外装はある程度キレイに出来ますが、内装が1番大変です!特に蓄積した頑固なヤニ汚れは、落とすのに苦労します…
Q2.車種や形状による清掃行程の違いついて
トラックには様々な形状がありますが、清掃工程は車種・形状によって大きく異なりますか?特に大型車は清掃が大変そうですね…
小型・中型・大型で作業工数は変わりますが、ほぼ工程は同じです。ちなみに、ハイルーフタイプの天井清掃はかなり大変です!
Q3.タバコの匂い取りついて
車内の隅々までついてしまった、タバコのニオイを取る方法は?
室内のヤニ汚れを落とした上で天井を分解して洗浄、蓄積した汚れを出来る限り清掃しています。※上記清掃は有料掃除でのみになります。
内装清掃を、写真でご紹介(ビフォアーアフターについて)
ここからは、実際に内装の清掃している模様を、写真でお伝えしていきます!
清掃の方法や雰囲気などが、ある程度伝わるかと思います。
室内の清掃

▲室内清掃では、車内に残るヤニ汚れを入念に落とします

▲蓄積したヤニ汚れは落とすのが大変…
天井の清掃

▲天井にもヤニ汚れがびっしり付いています

▲高圧洗浄機を使えば、この通り真っ白に!
光抗菌とは?仕組みやコーティングについて
近年、室内の除菌や抗菌に気を使っている方も多いと思いますが、「光抗菌」という抗菌方法はご存知でしょうか?
光抗菌とは、ウイルスなどの雑菌に対し光の力で抗菌する方法で、植物の光合成に仕組みが似ています。太陽光や蛍光灯などに含まれる「紫外線」を物質に照らすことで、特定の化学反応の反応速度を早める「光触媒」が機能して、除菌が行われます。
光抗菌に関する試験結果
ここまでの内容から「光抗菌は何に使われるの?」と思った方もいらっしゃるかと思います。実は、光抗菌に関する驚愕の試験結果があります。
光抗菌に関する商品を販売する「和興テクノ」の試験では、バスの運転席や座席に施工後、菌の繁殖状況を観察したところ、1年間の効果持続性が確認できたそうです!
▲1年間の効果持続性が確認されました!
トラック王国の光抗菌コート施工について
トラック王国では、上記の光触媒技術を採用した、光抗菌コート施工を実施しています。光抗菌コートをご希望の方は、車両購入時に併せてお申し込みが可能です。
光抗菌コート施工は1年間効果が持続します。施工済の状態で納車しますので、初日から安心してご乗車できます。
| トラック王国の光抗菌施工(税込) | |
|---|---|
| 小型 | 11,880円→特別価格11,000円 |
| 中型・増t | 14,080円→特別価格11,000円 |
| 大型 | 17,380円→特別価格11,000円 |
ご自身で施工したい場合はこちらをご確認ください!
現車確認について

▲現車確認はお気軽にお問い合わせください!
現車確認時の流れについて
ここからは、お客様が展示場で購入候補の車両を確認する、現車確認時に質問される点について尋ねてみました。
実際にお客様から聞かれた疑問点について、どんな内容があったかを、中部展示場に教えて貰いました!
Q1.現車確認について
現車確認時に、お客様がよく気にされるポイントは何でしょうか?
車両形状にもよりますが、お客様は仕事で使用されることを想定して、上物の動作や荷台・エンジンの状態・フレームのサビ、外装の状態などを気にされます。
「中古トラックを買うときは、どんな流れで手続きや購入、納車まで至るんですか?」このような疑問にお答えしていきます!
納車前点検と契約について

▲納車前にも問題が無いか確認します
納車前点検と契約とは?
現車確認が終わって、晴れてお客様が購入!という流れになりましたら、納車前点検が行われます。
納車前点検では、検品表と内外装チェックシートを再確認しています!その語、納車前チェックシートを用いて、検品内容に不具合が無いかをダブルチェックします。
納車前チェックシートの確認項目は、以下のようになっています。
- 納車前チェックシート抜粋
- 外装・内装洗車
- ナンバー・封印チェック
- 電装関連(ETCやホーンなど)
- 走行チェック(ブレーキの効き・ハンドルのブレなど)
納車時の疑問点を、スタッフに聞いてみた
ここからは、納車時にお客様が気にされているポイントなどを、スタッフに尋ねてみました。 実際に展示場で車両を購入する場合などに、参考にしていただければ幸いです。
Q1.納車時のご要望について
納車時に多い、お客様からの要望はどんなものがあるでしょうか?
車両にもう少し燃料を入れて欲しかった、写真とイメージが異なる、室内清掃をもっと進めて欲しかった、などのご要望をいただきました。
お客様からのご要望については、本社と協力して解決していく所存でございます!
Q2.書類手続き時の流れは?
お客様が納車後に書類手続きを依頼する際は、どんな点に注意すれば良いでしょうか?
納車後はお客様が円滑に名義変更出来る様に、事前の車庫証明申請をおすすめしています。
書類手続きについては不明点がある事も想定して、お礼の電話を兼ねて再周知しています
トラック王国では、お客様の最高の笑顔に挑戦していきます!
王国サービスについてのまとめ
今回の記事で、トラック王国のサービスについて理解できたのう。
納品されるまでにも、色々チェックが行われているトラー
チェックを重ねることにより、見落としが無いようにしているんじゃな。
このようなサービスもトラック王国の強みと言えそうですね。
姫にもタピオカ1年分をサービスして欲しいトラ!
そんなサービスは王様に頼んでください…



コメント